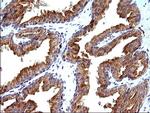
SCAMP2 Antibody in Immunohistochemistry (Paraffin) (IHC (P))

Search
Invitrogen
SCAMP2 Monoclonal Antibody (OTI2F1)
{{$productOrderCtrl.translations['antibody.pdp.commerceCard.promotion.promotions']}}
{{$productOrderCtrl.translations['antibody.pdp.commerceCard.promotion.viewpromo']}}
{{$productOrderCtrl.translations['antibody.pdp.commerceCard.promotion.promocode']}}: {{promo.promoCode}} {{promo.promoTitle}} {{promo.promoDescription}}. {{$productOrderCtrl.translations['antibody.pdp.commerceCard.promotion.learnmore']}}

Please note: We are reviewing Western blot images included in the antibody testing data in our catalog, including those provided by third parties. Unless expressly labeled or annotated as “raw-unedited”, Western blot images included in the antibody testing data in our catalog may have been edited, optimized or otherwise adjusted for presentation.
产品信息
MA5-26298
种属反应
宿主/亚型
分类
类型
克隆号
抗原
偶联物
形式
浓度
规格
纯化类型
保存液
内含物
保存条件
运输条件
RRID
靶标信息
Secretory carrier membrane proteins (SCAMPs) are proteins that are components of post-Golgi membranes. These proteins are implicated to function in membrane trafficking. In fibroblasts, SCAMPs are concentrated in compartments that are involved in the recycling of cell surface receptors and endocytosis. In neurons, SCAMPs are associated with synaptic vesicles, secretion granules and transporter vesicles. SCAMPs are composed of four central transmembrane regions and a cytoplasmic tail. Of the five known SCAMPs, SCAMPs 1-3 contain cytoplasmic N-terminal regions with NPF repeats. NPF repeats are found to interact with EH domain proteins that function in budding of transport vesicles from the plasma membrane or the Golgi complex. SCAMPs 4 and 5 lack the N-terminal NPF repeats. SCAMPs 1-4 are all ubiquitously coexpressed while SCAMP 5 is only detectable in the brain. Studies show that SCAMP 5 is expressed late in development which is coincident with expansion of mature synapses.
仅用于科研。不用于诊断过程。未经明确授权不得转售。
篇参考文献 (0)
生物信息学
蛋白别名: scamp 2; Secretory carrier membrane protein 2; Secretory carrier-associated membrane protein 2
基因别名: SCAMP2
Entrez Gene ID: (Human) 10066




